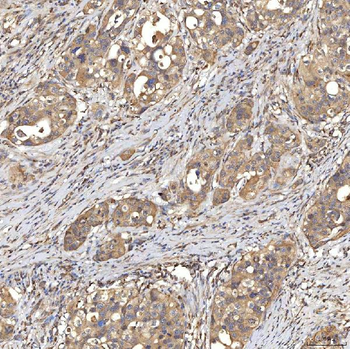
SIAE Antibody
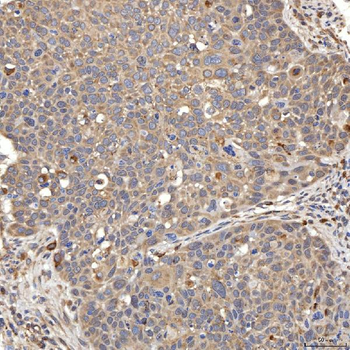
SIAE Antibody
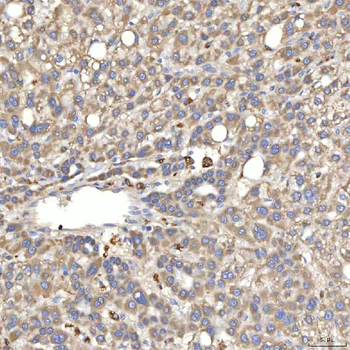
SIAE Antibody
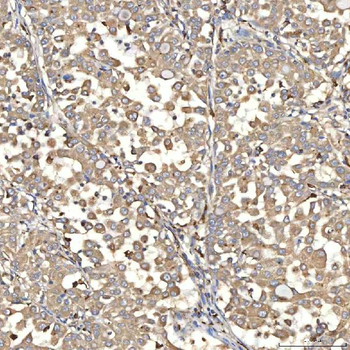
SIAE Antibody
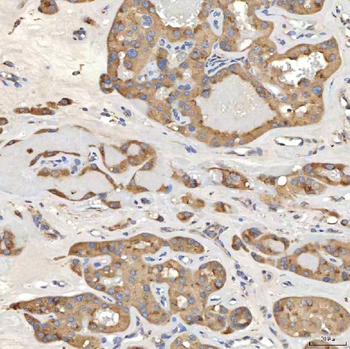
SIAE Antibody
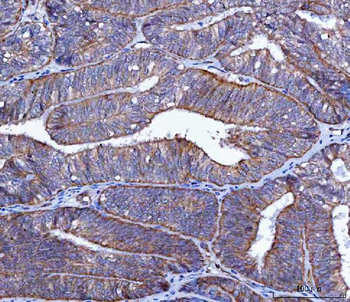
LIN41/TRIM71 Antibody

You have no items in your shopping cart.
Human Activin A Protein
Description
Research Area
Images & Validation
−| Application Notes |
|---|
Key Properties
−| Expression System | HEK293 |
|---|---|
| Target | Activin A |
| Reactivity | Human |
| Tag | Native |
| Molecular Weight | 13.0 kDa |
| Expression Region | Gly 311 - Ser 426 |
| Purity | 95% |
| Endotoxins | 0.1 EU per μg |
| Conjugation | Unconjugated |
Storage & Handling
−| Storage | -20°C to -70°C for 12 months in lyophilized state;. -70°C for 3 months under sterile conditions after reconstitution. For long term storage, the product should be stored at lyophilized state at -20°C or lower |
|---|---|
| Form/Appearance | Powder |
| Buffer/Preservatives | 0.056% TFA in 30% ACN |
| Disclaimer | For research use only |
Similar Products
−SIAE Antibody [orb1474858]
ELISA, FC, ICC, IF, IHC, WB
Human, Mouse, Rat
Rabbit
Polyclonal
Unconjugated
100 μgLIN41/TRIM71 Antibody [orb1402134]
ELISA, FC, IHC, WB
Human, Mouse, Rat
Rabbit
Polyclonal
Unconjugated
100 μgCBP20/NCBP2 Antibody [orb1786067]
ELISA, FC, ICC, IF, IHC, WB
Human, Mouse, Rat
Rabbit
Polyclonal
Unconjugated
100 μgHuman BMP and Activin Membrane Bound Inhibitor Homolog (BAMBI) ELISA Kit [orb777458]
Human
0.16-10 ng/mL
0.061 ng/mL
96 T, 48 T

Quality Guarantee
Explore bioreagents carefree to elevate your research. All our products are rigorously tested for performance. If a product does not perform as described on its datasheet, our scientific support team will provide expert troubleshooting, a prompt replacement, or a refund. For full details, please see our Terms & Conditions and Buying Guide. Contact us at support@biorbyt.com.

SDS-PAGE analysis of Human Activin A protein

Immobilized Human Activin A, premium grade (Cat. No. orb16656) at 5 μg/mL (100 μL/well) can bind Human ACVR2A, Fc Tag (Cat. No. orb1101193) with a linear range of 0.4-25 ng/mL (QC tested).
Documents Download
Request a Document
Protocol Information
Basu, Moitri et al. Invasion of ovarian cancer cells is induced byPITX2-mediated activation of TGF-β and Activin-A Mol Cancer, 14, 162 (2015)
Human Activin A Protein (orb16656)
Participating in our Biorbyt product reviews program enables you to support fellow scientists by sharing your firsthand experience with our products.
Login to Submit a Review